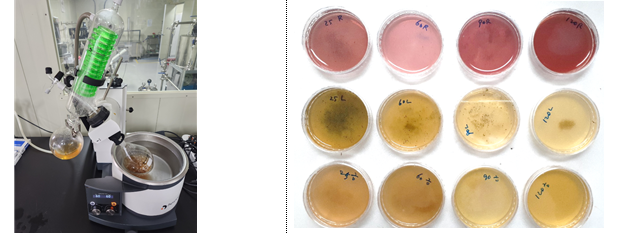
2024??11???곗묶

Our Story
Hibisco began with a single golden blossom. Golden Hibiscus carries abundant antioxidants and gentle energy, offering beauty that radiates from within.
We carefully capture the power of nature in each petal, creating a quiet luxury that endures beyond time.
"A quiet luxury that endures beyond time."